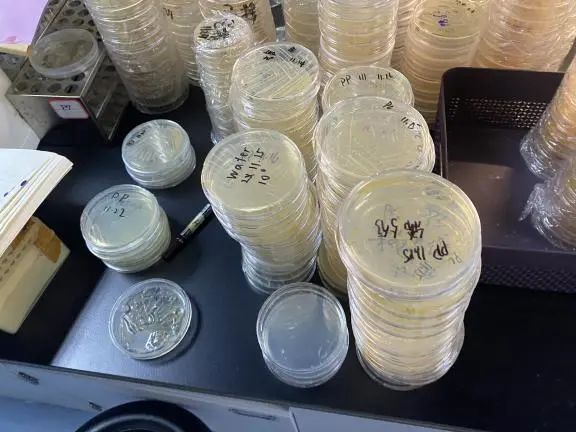
图片

National Award Style | Zhu Chengrui -- Accompanied by Biology, Climbing the Academic Summit
Publisher:赵亚囡
Release time:2022-12-09
Number of views:84
01Personal Profile
Zhu Chengrui is a 2020 undergraduate majoring in biotechnology at HaideCollege of Ocean University of China. The academic year 2021-2022 ranks the third in comprehensive test results and the first in academic performance. He has won the first scholarship of Ocean University of China, the title of outstanding student of Ocean University of China, the second prize of the 8th Internet plus College Students Innovation and Entrepreneurship Competition of Ocean University of China and other awards. Preside over and complete one project as SRDP project leader, and participate in another SRDP project.

02Experience sharing
(1)Learning&Experimental Experience
For the study of biotechnology, the difficulties are mainly reflected in two aspects.
The first is English learning. Biology is a subject with very high requirements for English. Professional English needs no more words, and everyday English is also very important. For example, you may need to communicate in English when attending a group meeting. Therefore, it requires us to practice our English well in daily life.
I think the training in foreign courses and the learning of CET-4 and CET-6 can greatly improve our English level. Taking online courses as an example, I am sorting out relevant vocabulary in my daily study. I usually learn the word cards of each module before browsing the course video, understand the professional vocabulary and its meaning, and then add them to the word book to sort out and recite them. For words commonly used in daily life, you can record them in the special vocabulary book for CET-4/CET-6. If it is a professional word that cannot be translated by the translation software, you can search on the Internet (Bing International is recommended) or ask the Chinese teaching assistant.
The second is experimental skills. Like other science and engineering subjects, experiment is an indispensable part of biology. In the face of each experimental course, we should do a good job of experiment preparation and take each experimental report seriously, so as to exercise our experimental ability.
As for the SRDP project, I suggest that students take part in the sophomore or junior year. In the freshman year, we knew little about the knowledge related to the experiment. If we started the SRDP project, we need to learn a lot of knowledge in a short time, which is easy to bring greater pressure. In addition, there are more courses in the freshman year, less time to do projects after class, and long commuting time between campuses, which will easily bring heavy burden to students, and will also affect the continuity and effect of the experiment. Therefore, I recommend that students wait until their sophomore or junior year to participate in the SRDP project.
(2)Practical activities
In the 2021-2022 academic year, I served as the class study committee member in terms of social practice activities, and participated in winter vacation team social practice activities and summer vacation personal social practice activities. In terms of voluntary services, I, as a special volunteer in Luka, provided online support and education. At the same time, as a volunteer for epidemic prevention and control in the college, I assisted in epidemic prevention and control. I spent 32 hours of volunteer service.
In this semester, I also served as the assistant teacher of the 2021 instrument use and safety and the 2022 laboratory safety courses of the Institute of Marine Life of HaideCollege. Generally speaking, there are two conditions to be a teaching assistant: one is to have studied the course, and the other is to have a certain understanding of the content of the course. If any student wants to be a teaching assistant of relevant courses, he or she must work harder at ordinary times.
03Future Outlook and Message
After winning the national scholarship, I have more confidence in myself. Looking back on my sophomore year, I felt confused. I really appreciate my friends' help and encouragement. The road of study and scientific research is not plain sailing. In many cases, the most important thing is not the result, but that you have really worked hard.
For the future, I think we need to establish a clear goal and plan. Of course, the goal is important, but it is more important to focus on the present and try to do everything well. In my end is my beginning, I believe that to do what should be done well, success is a natural thing.



